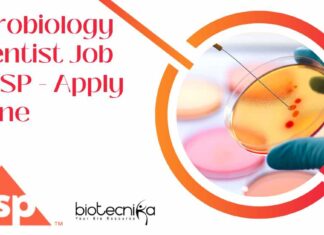
Microbiology Scientist Job at USP – Apply Online Microbiology Scientist Job at USP

Hershey’s Research Scientist R&D Job – Food Science & Tech Apply...
Hershey's Research Scientist R&D Job - Food Science & Tech Apply Online
Sr Research Scientist R&D In Nutrition
Posted Date: Feb 4, 2025
Requisition Number: 124306
Location: Surendra...
Amgen BSc & MSc Life Sciences Associate Job Opening, Apply Online
Amgen Associate Job Opening, BSc & MSc Life Sciences Apply Online
PC Triage and Intake Associate
India - Hyderabad
JOB ID: R-205446
LOCATION: India - Hyderabad
WORK LOCATION TYPE:...
Summer Internships 2025 at IIT Palakkad – Apply Online
Summer Internships 2025 at IIT Palakkad - Apply Online
IIT Palakkad has a summer internship program which aims at introducing undergraduate and postgraduate students to research...
Biotecnika Times Newsletter 03.02.2025 – CCMB, IISER Pune Summer Training Program...
CSIR-CCMB Summer Training Program 2025 – Applications Invited Online
Apply for the CSIR-CCMB Summer Training Program 2025 to gain hands-on research experience.
IISER Pune Summer Student...
CSIR-CCMB Non-Medical Project Vacancy & Non-NET Project Vacancy – Apply Online
CSIR-CCMB Non-Medical Project Vacancy - Apply Online
CSIR-CCMB Non-Medical Project Vacancy - Apply Online. CSIR-CCMB Non-Medical Project Vacancy - Apply Online. Interested and eligible applicants...
Apply For SURGE-2025 at IIT Kanpur – Students-Undergraduate Research Graduate Excellence...
SURGE-2025 IIT Kanpur Registrations - Apply Online
SURGE-2025 IIT Kanpur Registrations - Apply Online. Interested and eligible applicants can check out all of the details...
12+ TIGS Life Sciences Project Research Jobs – Apply Online
TIGS Life Science Project Research Jobs - Apply Online
TIGS Life Science Project Research Jobs - Apply Online. Interested and eligible applicants can check out...
CSIR-IICB MSc Biotech Non-NET Project Vacancy – Apply Now
IICB MSc Biotech Non-NET Project Vacancy - Apply Now
Advertisement No. : R&C/579/2025
Date of Advertisement: 04/01/2025
Vacancy Code: 5792516
Position: Project Associate-I
No. of Vacancies: 1
Walk-in Interview on:...
Project JRF Position For MSc, MTech at Regional Centre for Biotechnology,...
RCB Project Positions 2025 - MSc, MTech Apply Online
Advt. No. 05/Project/2025/HR
Interview for ‘Project-JRF’ Position
Title of Project: Genetic and translational landscape of Candida glabrata pathogenesis...
Govt BSc Life Sciences Jobs at Tea Research Association, Attend Walk-In
Govt BSc Life Science Jobs at Tea Research Association, Attend Walk-In
Tea Research Association
Situation Vacant
Advertisement No.: 3622/TOK/G.25/1001
Date: 31st January, 2025
Positions Available under the Bomlife Pvt....
Sanofi Life Science Analyst Job Opening – Apply Online
Sanofi Life Science Analyst Job Opening - Apply Online
Analyst - Transparency Reporting
Location: Hyderabad
Time Type: Full-time
Posted On: Posted 7 Days Ago
Time Left to Apply: End...
Microbiology Scientist Job at USP – Apply Online
Microbiology Scientist Job at USP - Apply Online
Scientist II, Microbiology
Location: Hyderabad, IND
Job Category: Publications
Job Type: Full-Time
Req ID: SCIEN00262
Description
Brief Job Overview:
This is a hands-on, non-supervisory...
Beckman Coulter Life Sciences Development Scientist Job For Cell Biology, Apply...
Beckman Coulter Development Scientist Job For Cell Biology, Apply Online
Development Scientist I (Bangalore)
Company: Beckman Coulter Life Sciences
Location: Bangalore, Karnataka, India
Category: Science
Job Id: R1280584
Do you...
Scientist Position Available at Cytiva – MSc Life Science & Microbiology...
Scientist Position at Cytiva - MSc Life Science & Microbiology Apply Online
Scientist I, Bangalore
Company: Cytiva
Location: Karnataka, India
Category: Science
Job Id: R1280857
The Scientist I for Cytiva...
Research Technician Job at Beckman Coulter Life Sciences! Apply Now!
Research Technician Job at Beckman Coulter Life Sciences! Apply Now!
Research Technician-II (Location - Bangalore)
Company: Beckman Coulter Life Sciences
Location: Bangalore, Karnataka, India
Category: Science
Job Id: R1282892
Do...